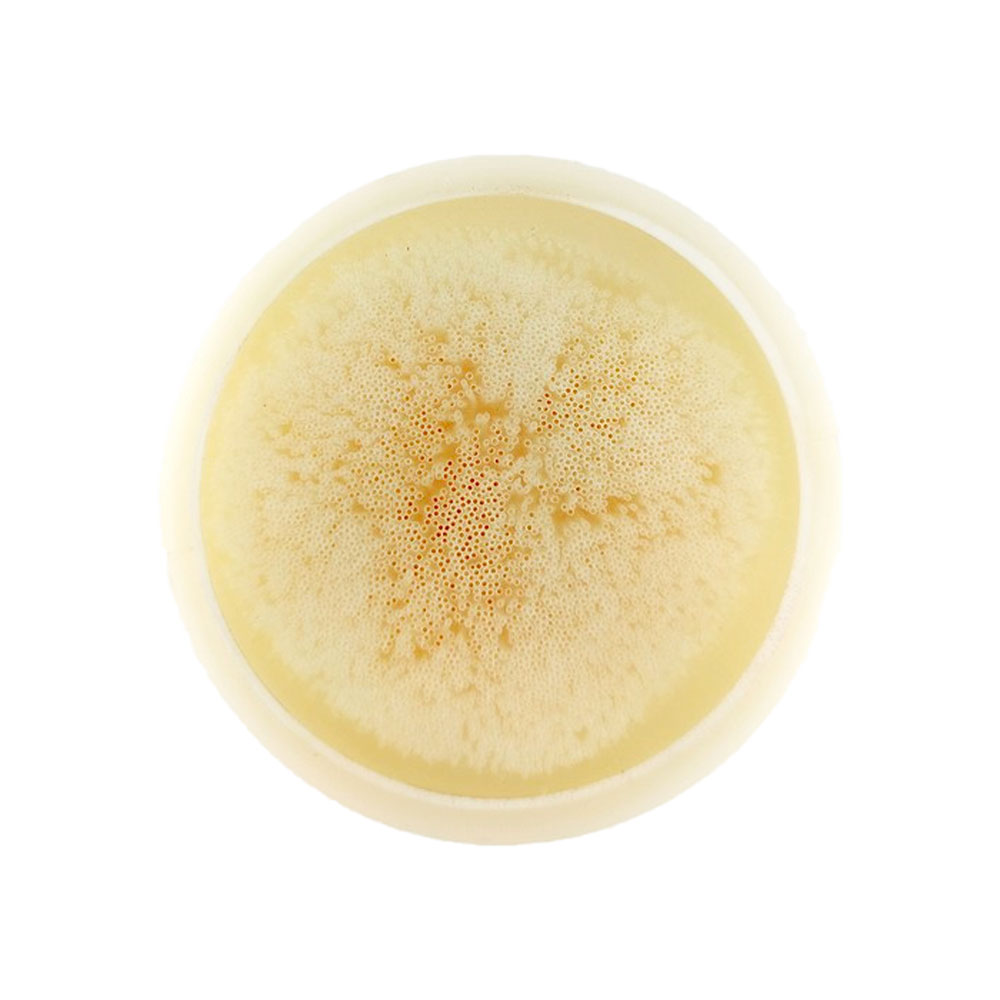

Розстрочка та кредит

м.Дніпро, просп. Олександра Поля 90

У відділення / Поштомати

Доставка по адресу

У відділення

Комплект картриджів Raifil UF-11 + IL10W-C BOX — це ефективне рішення для очищення питної води, що включає ультрафільтраційну мембрану та постфільтр. Даний набір забезпечує комплексне очищення води: видаляє механічні домішки, бактерії та покращує органолептичні властивості води.
Ультрафільтраційна мембрана UF-11 затримує найдрібніші забруднення, включаючи бактерії та зважені частинки до 0.02 мкм, не змінюючи мінеральний склад води. Постфільтр IL10W-C виконує фінальну стадію очищення — покращує смак, усуває запахи та залишковий хлор.
Комплект підходить для стандартних колб формату Slim Line 10" (2.5"x10") і сумісний з більшістю побутових проточних систем.
Переваги комплекту Raifil UF-11 + IL10W-C BOX:
- Двоступеневе очищення — мембрана + постфільтр для максимального результату
- Видалення бактерій і зважених частинок — завдяки UF-мембрані
- Збереження корисних мінералів — без демінералізації води
- Покращення смаку та запаху — завдяки вугільному постфільтру
- Універсальний формат — підходить до більшості систем Slim Line 10"
- Південнокорейська якість — надійні матеріали та стабільна робота
Часті питання FAQ
Чи видаляє комплект Raifil UF-11 + IL10W-C BOX бактерії?
Так, UF-мембрана ефективно затримує бактерії, зважені частинки та інші мікрозабруднення.
Чи зберігаються мінерали у воді?
Так, на відміну від зворотного осмосу, UF-мембрана не видаляє корисні мінерали.
Чи підійде комплект Raifil UF-11 + IL10W-C BOX до мого фільтра?
Так, якщо у вас стандартні колби формату Slim Line 10" (2.5"x10"), комплект буде сумісний.
Чи можна встановити самостійно?
Так, встановлення не потребує спеціальних навичок і виконується швидко за допомогою стандартного ключа для колб.
Чи прибирає постфільтр запах і присмак хлору?
Так, вугільний постфільтр ефективно покращує смак, усуває запахи та залишковий хлор.
Поради з експлуатації
- Для ефективного комплексного очищення води використовуйте комплект Raifil UF-11 + IL10W-C BOX з попередніми фільтрами механічного очищення.
- Замінюйте комплект кожні 6–12 місяців залежно від якості води
- Перед встановленням промийте картриджі згідно з інструкцією
- Використовуйте тільки з холодною водою (4–40 °C)
Купіть комплект Raifil UF-11 + IL10W-C BOX — це простий спосіб отримати безпечну, чисту та приємну на смак воду.
- Мембрана ультрафільтрації Raifil UF-11 — 1 шт.
- Постфільтр Raifil IL-11W-C-EZ с гранулированным активированным углем — 1 шт.
- Фітинги для підключення картриджів у системі — 4 шт.
Немає відгуків про цей товар, станьте першим, залиште свій відгук.

Немає питань про даний товар, станьте першим і задайте своє питання.

- Оплата за реквізитами
- Оплата online (Visa/MasterCard)
- Безготівковий розрахунок
- Оплата частинами